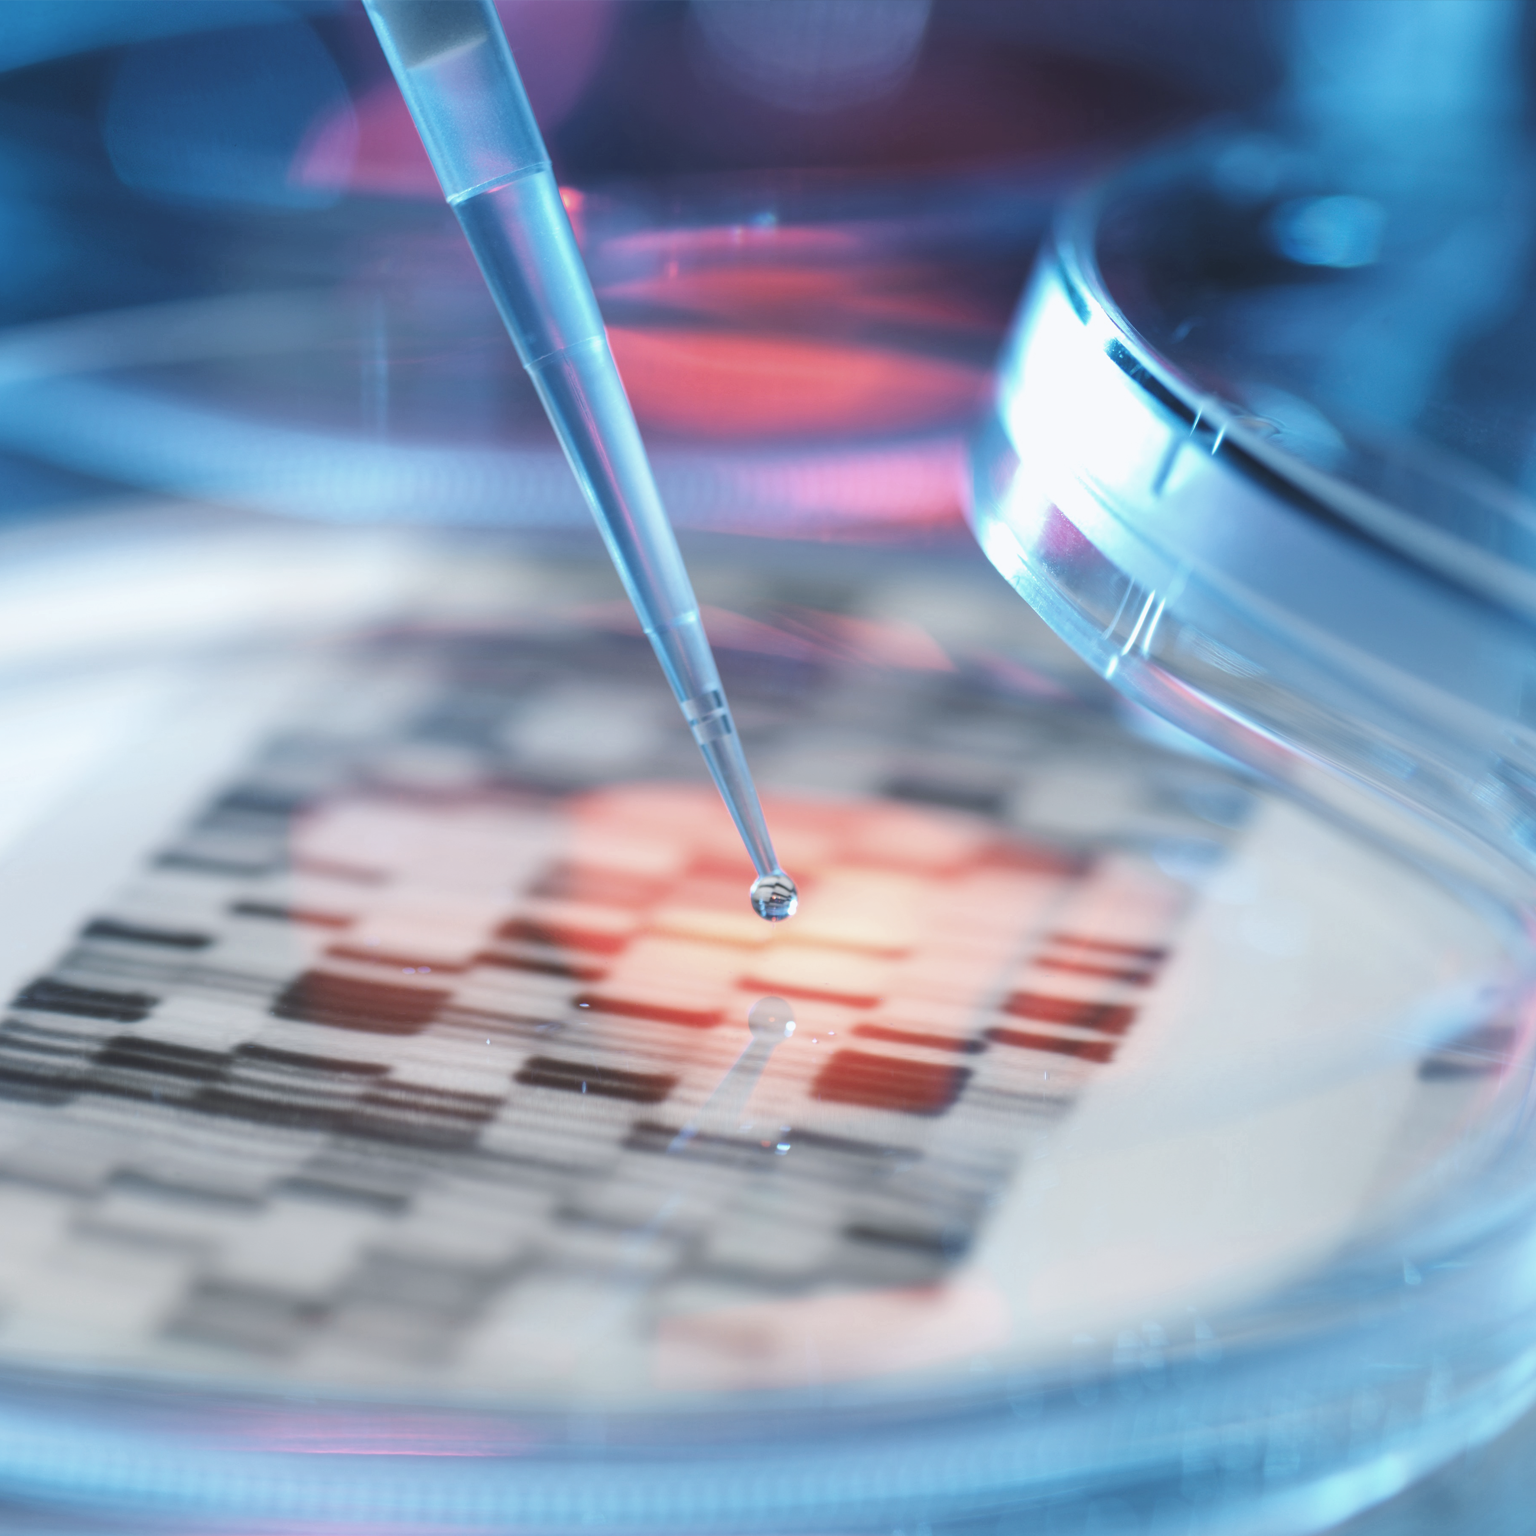
Forward Thinking on the Bio Revolution with Jason Kelly and Dr. Michelle McMurry-Heath

In this episode of the McKinsey Global Institute’s Forward Thinking podcast, hosts Michael Chui and Anna Bernasek interview Diane Coyle about the digital economy, its impact on productivity, and what’s left out of the analysis when we focus only on GDP as a measurement of growth. Diane’s latest book, Markets, state, and people: Economics for public policy, is available now from Princeton University Press.
This conversation was recorded in February 2021 and has been edited for clarity and legibility. Subscribe to the series on Apple Podcasts, Google Podcasts, Spotify, Stitcher, or wherever you get your podcasts.
Michael Chui: Hi, and welcome to Forward Thinking, I’m Michael Chui.
Anna Bernasek: And I’m Anna Bernasek. And Michael, I’ve got a question for you right off the bat. How much did you pay to use social media and email last year?
Michael Chui: What? Pay? For social media and email?
Anna Bernasek: Yeah, come on, I’ve seen how much you’ve been tweeting. It must’ve been enormous, what was your bill?
Michael Chui: Well, a bill, what? What are you talking about? Nobody pays for email or social media.
Anna Bernasek: Ah, so how do we actually measure the value that we get from these things?
Michael Chui: Well, I mean, supposedly I should get additional productivity out of emails. I’m not really sure if that’s the case. And I definitely get a lot of enjoyment from connecting with friends and family and others on social media. But I think I get what you’re getting at—because we’re at the McKinsey Global Institute, how do we measure what impact these things have on the economy?
Anna Bernasek: Right. When you think about it, more and more of what we do each day in our work and in our lives, we don’t actually pay for, well, at least not directly, right? Think about maps or messaging, I don’t know, music online, learning, video conferencing and all that sort of stuff. And when something doesn’t have a price, it isn’t measured as economic activity.
Michael Chui: I guess that means it’s not just social media, but everything from volunteer work, to looking after an aging relative, to housework. In other words, when we focus on GDP, we’re missing a big part of the picture.
Anna Bernasek: That’s absolutely right. And that means if we can’t tell what’s going on in the economy, we can’t make good decisions. I spoke with Diane Coyle earlier, who thinks about all these issues around the digital economy, its impact on productivity, and the measurement of growth.
Diane is a professor of public policy at the University of Cambridge, and won the 2007 Indigo Prize for writing an essay calling for improved measurements of national well-being. She also authored several books, including GDP: A Brief But Affectionate History, and she blogs as the Enlightened Economist.
Michael Chui: Well, who doesn’t have affection for GDP? No, but really, this sounds incredibly relevant to the point we’re at right now, moving from the pandemic, hopefully, to a recovery. You know, we at MGI have been studying this for quite some time, and have done a bunch of research on the post pandemic economy. But I’d love to hear what Diane has to say, number one, about how to measure GDP, but also how the economy might evolve going forward. Let’s listen.
Anna Bernasek: Diane, welcome to Forward Thinking.
Diane Coyle: Well, it’s great to be here talking to you, Anna.
Anna Bernasek: Diane, where are you talking to us from today?
Diane Coyle: I’m sitting here in Cambridge, in my home office in Cambridge, looking out at gentle snowflakes falling past the window. It’s that time of year.
Anna Bernasek: Ah, that sounds lovely. My daughter just started a university course in economics this year, and I was really pleased to discover she’s using a program called Core, which I think you played a role in developing. Can you just tell us a little bit about that?
Diane Coyle: I’m really glad that she’s using that, it’s great to hear. This started back in 2012, so a few years after the financial crisis. And there was a lot of discussion among economists at the time about our performance, the performance of macroeconomists who’d failed to forecast that the crash was going to happen, and what the subsequent effects on the economy were.
And a lot of concern among employers that I was speaking to, that the students they got from economics courses, the graduates, were incredibly able and technically adept, but they were not informed by anything that was really happening in the economy currently. They didn’t know any economic history.
And they were sort of half-baked products, if you like. And this was obviously an issue for people teaching economics courses. I organized a conference that was hosted by the Bank of England and the Government Economic Service here in the UK, and one of the speakers there was Wendy Carlin, at UCL in London, had started thinking about devising a course that would put what was happening in the economy front and center.
That would focus around the big questions that students want to know about, be it financial crisis, inequality, what was happening to the environment, unemployment, and teach the tools that we use around that and include economic history and the history of ideas. They convened a very large group of economists around the world who volunteered their time.
And we put together this text called The Economy, which is a textbook but also a free online version of the course with interactive materials. And it’s now been taken up by hundreds of universities around the world as their introductory course, and it’s going from strength to strength. But that’s what students care about. Students are incredibly motivated by the big problems and passionate about solving them.
Anna Bernasek: It’s really so practical and relevant. I wish it had been available when I studied economics. And that approach to framing problems and our understanding of the economy seems really central to your work right now, particularly in the area of measurement.
Diane, you’re known for your critique of how we have measured and valued economic activity up to now. You’ve written about how transactions are counted in dollars, but that accounting really leaves out important things like physical resources, intellectual resources, and valuable activity that isn’t traded for money. Can you tell us a little bit more about what’s wrong with the way we’ve been measuring GDP? And really, what should we be doing instead?
Diane Coyle: First of all, sustainability. In a book I wrote after the financial crisis called The Economics of Enough, I started to worry about the sustainability of the market economies in the broad sense, not just the natural environment but social and financial and political sustainability, as well.

Will productivity and growth return after the COVID-19 crisis?
And I concluded that we didn’t have the measures that we could look at in the way that policymakers need information, or anybody in business needs the information to know how to manage effectively, that we didn’t have those. And because I’ve always been interested in public policy and done lots of policy roles, I started to think about what did we mean to say—policy should make things better?
What was better? And how did we understand that? I got into thinking about GDP, gross domestic product. It turns out that most people have no idea what it is or how it’s put together. My next book was a history, explaining the concepts and how it had come about. But there are two areas I’m interested in.
One is capturing better this idea of measures of sustainability. We have a framework called the wealth economy framework, and the analogy is with the corporate balance sheet. You couldn’t run a company just looking at cashflow and profit and loss. You need to understand what’s happening to the balance sheet, as well.
And that tells you about the reserves and the assets and the long-term viability of the company. It’s just the same for any national or subnational economy, you need to know what the assets are that you have and how they will generate prosperity in future.
The other aspect I’ve been interested in for a very long time, way back into the 1990s, is the digital transformation of society. And these two interests come together because digital is changing the way that we create value in society. Where in value chains does that happen? Who gets the benefits? And is there a gap between what we measure in dollars and the economic welfare, the benefits, that people can get from these digital services?
And a simple way to think about that is to think of all these zero-priced products that we use now, the social media companies, Google search, all of the platforms provided, all of the free apps that we have on our smartphones so we don’t need to buy cameras and get photos processed anymore and we don’t need to buy watches or road atlases.
But also, things like not going to the High Street to stand in line at the bank but being able to do online banking. And so there’s a wedge opening up between the categories and the dollar values that we can assign to activities and the benefits that people are getting and who is getting those benefits, as well. It sounds incredibly nerdy to be interested in the economic statistics, but they’re the lens we have on the world, they tell us how to make decisions, and how to even think about what we mean by economy and by prosperity.
Anna Bernasek: Could you put that into context for our listeners? If you’re a CEO or a policymaker, why do you care about whether we measure GDP correctly or not?
Diane Coyle: You care because this is how decisions get made. If you think about how policies are often justified, it’s in terms of, well, they will generate x-percent of growth and x-percent of jobs. And that’s important. GDP really matters because it is correlated with things that we really care about—but it’s not the whole story at all.
It doesn’t tell you about the extent to which we are using tomorrow’s resources to consume today and, therefore, will we be as well-off tomorrow as we think we are? Actually, there are lots of signs in our societies that people are starting to doubt whether their children will be as well off as they are.
That’s, I think, a first since the dawn of capitalism and not a very healthy situation. And so you need the other indicators to be able to make good decisions, and that’s true of policymakers and it’s true of business also. But the other issue is about distribution and who’s getting the benefits of all the innovations that our societies are generating.
Before the financial crisis, people hadn’t paid that much attention to distributional matters. We looked at the average GDP growth rate, perhaps sometimes per capita, but that’s still an average, and not paid enough attention to distribution.
Subscribe to the Forward Thinking podcast
I think because policymakers had not been paying attention to that, we got ourselves into a situation where very many low- and middle-income people actually didn’t see any gains in their incomes for a very long period of time. And not surprisingly, that has generated a lot of discontent, and we’re seeing that playing out now in political upheaval. The framework of measurement is incredibly important for good decisions in business and good policy decisions.
Anna Bernasek: It sounds like we’ve been flying blind, measuring only part of the economy, but not really paying attention to some of the very significant components.
Diane Coyle: Yes, decreasingly so because a lot of economists are now working on these issues, and there are new data sources. For example, during 2020, we saw a lot of people very quickly working to use new data sources to understand what’s happening to the economy real time, using things like credit card payments and movements of money through the financial system, mobility data, and so on, to get a real time picture of the economy. That’s much more geographically fine-grained as well, so that you can understand it in different places. But there are still very big gaps. And I think this is a really exciting research agenda because it’s not just about measurement, it’s about how you think about things.
To give a couple of examples, we’ve got this concept called the production boundary. It defines what we count as being in the economy and in GDP. It’s never included unpaid work in the home. And that has mattered during the pandemic, because there’s a lot more going on at home and the burden of that unpaid work has been unevenly distributed, more for women doing all the extra schooling or looking after things at home.
And then the other thing is nature. We have not included nature in our definition of what counts as the economy. A colleague of mine, Professor Sir Partha Dasgupta, has just put out a big report about biodiversity. And why we should be counting the depletion of biodiversity? For the very hardheaded reason this is going to hit agricultural productivity and food supply chains. The yields of crops will be falling because we have had a catastrophic fall in bee populations and pollination isn’t happening. These things, they sound like cuddly options but actually they’re absolutely essential.
Anna Bernasek: Diane, when you mention unpaid housework being ignored, it reminds me of Marilyn Waring’s book, If Women Counted (1988, Harper & Row). These issues really have been around for a while, and I guess sustainability isn’t a new concept either. Why do you think it’s important to address these issues now?
Diane Coyle: That’s a really good question. I suppose part of the answer is that environmental impacts are catching up with us. Keynes had this famous saying, “In the long run, we’re all dead.” And people always took it to mean only concentrate on short-run issues. But since he wrote that, we are now in the long run. The impacts of climate change in certain areas with wildfires and unpredictable climate events, or the impact of biodiversity on food production—we are now seeing that impact people’s lives and future prosperity. I think that’s part of it. But I think the digital changes also have helped reopen all these broader questions.
This came about because there was a sense among digital companies and policymakers that there were important changes happening that weren’t being captured, and this, I think, reopened the whole question about what gets measured.
A parallel I often use is that in the 1885 Annual Abstract of Statistics for this country, the UK, there are 120 pages, of which about 20 cover the Industrial Revolution, the mines, the factories, the railway lines, and the canals. And the other 100 are all about the detail of agricultural production.
This was at the height of the dark Satanic mills that Blake wrote about, that you could not miss that the Industrial Revolution was happening and yet the statistics haven’t caught up. And so there’s a framework that lags behind what’s happening in the economy and often it doesn’t matter. But at times of technological change as we’re seeing now, suddenly we realized it doesn’t fit, and we need to rethink that framework.
Anna Bernasek: The pace of technological change only seems to increase. Can you tell us more about the issues we face in measuring the digital economy?
Diane Coyle: Sure. There’s a really wide range of questions that we need to think about. And I started to mention some of them.
And you might ask, well, why do these matter? The examples I gave with things like free apps so we don’t have to buy diaries and watches and calculators and all of the other things that you can now use your phone for.
This matters because we construct a price index that tells us what’s happening to real GDP. We can count the dollar amount at the total relatively easily, although it’s still quite a complex process. But we want to put that in real terms to understand, taking account of general inflation, and understand whether people are, in a fundamental sense, as well off as they used to be.
You’ve got to get a price index to do that. What price are we meant to capture? If you just looked at price of cameras, then that might not have fallen very much. Are we trying to measure the price of cameras or devices or the ability of people to capture images and look at them again?
Constructing a price index has become very hard. With some coauthors here, I looked at the price of telecommunication services. And this had flatlined for a few years, which anybody in telecoms thinks is just bizarre because of the technological improvements that have happened over the period and the vast amount of data usage, how much that’s gone up.
And so we constructed an alternative index that looked at the price per unit of data, per bit of data, that people were using, and rather than being flat, it declined by 90 percent. We don’t really have a good idea about what’s happened to prices or even what concepts we’re trying to capture when we think about real GDP.
There are the boundary issues I talked about, and then there are questions like data that everybody says it’s really important, and that’s obviously true. The gap between companies that use data well and those that don’t in terms of productivity and profits is really widening. But we don’t even know what a unit of data is.
Should we be measuring bytes that people are using? Well, clearly, the content matters too. And where is it? And where is it flowing? There are no statistics on this. Should we be counting it in trade figures? Who knows? The conceptual issues are really hard—and then we’ve got to start trying to collect the statistics once we’ve got concepts pinned down. It’s going to keep me occupied until I retire. It’s a really fascinating but also big set of questions.
Anna Bernasek: Wow, retirement. That seems as if it will be less distinct than ever, as people continue to be productive while they age. I mean, measuring and understanding productivity is full of puzzles. You know, we’ve seen this trend of decelerating productivity growth in the US and also in Europe. How do you think digitization is affecting that? And will we ever capture the potential benefits of digital technology?
Diane Coyle: My fear is that we’re underestimating it a bit because of measurement issues. But there are lots of factors too. One of them is the one I just mentioned about how different companies are able or not to undertake the organizational changes and use the data that’s becoming available.
We’re in a period when the quality of company management makes a lot of difference to productivity, and there’s a fat tail of companies that are not keeping up with the frontier. But there are also broader factors, like demography, like the fact that in many markets in many countries, there’s been an increasing concentration and a decreasing competition. I don’t think the productivity issue has just one cause, I think there will turn out to be many causes.
Anna Bernasek: You know, here at MGI, productivity is a special focus for us. Our latest research has been looking at the impact of COVID and the pandemic on productivity. And actually, there might be something good to come out of this terrible disaster that we’ve all been living through.
Because when we look at it, we’re anticipating the potential for accelerating productivity growth, in part because of the hard lessons and adaptations forced on us by the pandemic. I wonder what you’re seeing on that front, and whether you’re seeing any trends?
Diane Coyle: It’s a really interesting question, Anna, and I think it will be quite a mixed picture, myself. There’ll be some areas of the economy where automation progresses faster than it otherwise would. While that means an increase in productivity, of course, a loss of jobs to go along with that.
And so that’s got some policy implications, and some well-being implications for the people involved. But on the other hand, there are many companies that have had no revenues and don’t have the money to invest in the new equipment. I think it will widen the gap between different types of company or sizes of company.
When it comes to the kinds of occupations that you and I do, where there are knowledge economy jobs, we’ve discovered that we can be much more productive in some ways, fitting in lots of meetings, not having to travel. But my view is that there’ll be swings and roundabouts there, that there’ll but some loss of productivity from a reduction in face-to-face contact.
Because I think that personal interaction, where you can interrupt more easily or you can chat as you’re going down the corridor, and there’s not the formality or barriers to the free exchange of ideas that exist online, no matter how good the technology. My bet is on the long term impact on productivity in desk-based jobs actually not being very large. But I might be wrong, we’ll find out. I must say, I can’t wait to get back into the office.
Anna Bernasek: Okay, Diane, so if you sit back then, and you look at the pandemic experience that we’ve had, do you see it as a temporary blip, or will it lead to more fundamental changes?
Diane Coyle: It’s probably a bit early to be definitive about this because we’re not out of the woods yet. It’s also clearly a very big negative shock to the economy, and again, we’ve not seen the full implications of that play out in unemployment and bankruptcies.
For example, all of those companies that have taken government support loans, we’re going to find out which of them can be repaid and which companies are going to go bankrupt. And there’ll be a debt resolution issue for both personal debt and corporate debt. All of that has yet to play out.
The difference that I detect that is supported by opinion polls is that there is a real appetite for change now. If you look back at episodes of these periods when there has been technical change and some big cataclysmic event in the economy, things end up being quite different a bit later.
Not necessarily immediately. Things work out for a few years. But then ultimately, they turn out to be big turning points. Perhaps it’s just wishful thinking on my part, but the appetite that I detect is for a change towards a much broader framework for how we think about what’s making people better off, and this is, as I said, what I’m interested in. But the focus on access to nature, a broader understanding of well-being, a focus on mental health, understanding distributional implications of the way that value creation is altering—I think these will become much more important.
Anna Bernasek: Well, that sounds really hopeful to me. How about the labor market, though? How should we be thinking about inequality? Isn’t a lot of the equality we see tied to lost jobs and low wages? I mean, and this really seems to have only gotten worse during the pandemic.
Diane Coyle: Oh, it absolutely is and it worries me greatly. Because if you think back to previous recessions, the late ’70s and early ’80s or the early 1990s, those are the periods when we saw a really big shake out in the labor market, with deindustrialization. And the consequences of that are still with us.
Because it was geographically focused, it affected the livelihoods of people with skills that were not transferrable to the kinds of jobs that were growing. That was the origin, I think, of the kinds of areas such as the Rust Belt, or the North of England. And those are the problems that are still with us.
These are still very deprived areas. It’s where we see what Anne Case and Angus Deaton call deaths of despair in the US. It’s where all of these multiple problems of poverty, poor housing, poor health, lack of access to infrastructure, poor quality local schools and hospitals, all of those interact together.
It’s a world of a kind of vicious spiral for those places. On the other hand, big cities and people in jobs that use the kinds of cognitive skills have been doing very well. The tendency has been greater inequality. We had no good public policy response to that disruption the last two times around.
And so in my more pessimistic moods, I wonder if there’s really an appetite among policy makers to tackle it better this time. Or an understanding of the scale of the problem, now that we’re a generation on and the pandemic is exposing those inequalities in a very cruel way. Because it’s people in areas of poverty and ill health who have the highest mortality rates.
Anna Bernasek: If I were to sum up what you’ve told us today, you’ve said on the one hand, there is cause for optimism because there’s a movement of people who really want to deliver widespread benefits across segments of our society. But on the other hand, the challenges of measurement and decision making are huge, particularly on a subject like inequality. How can we reconcile those two points of view?
Diane Coyle: I veer between being optimistic and pessimistic about it. There is a possibility that we get the political leadership that can trigger that sense of cohesion and pulling together that would help rebuilding. We saw that in the late 1940s and early 1950s, and that paved the way for what economists call “the thirty glorious years of growth” in the postwar era. There was a lot of investment, and there was that sense of national cohesion. On the other hand, if we don’t get that sense of cohesion, everybody being in the same boat and pulling together, then I think we could be in a world of potential conflict and dark times. And we’ve already seen in many countries quite a lot of political polarization that needs to be addressed and overcome.
Anna Bernasek: It certainly feels like we’re at a critical turning point. Well, Diane, thank you so much for joining us on Forward Thinking. It’s been a real pleasure.